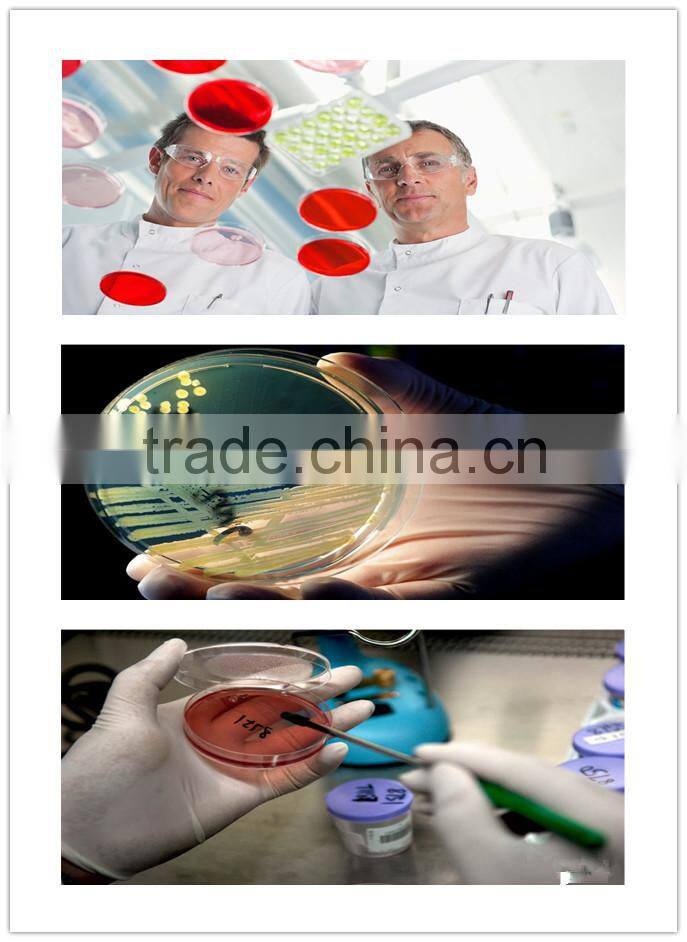
90*15mm plastic petri dish two-compact

Home > Products > PETRI DISH > 90*15mm plastic petri dish two-compact
90*15mm plastic petri dish two-compact
Negotiable
/ Piece
10000 Pieces(Min. Order)
- Ningbo Port
You May Like
Product Details
| Brand Name | Biolife | Model Number | JDF 1001 | |
| Place of Origin | Zhejiang, China |
Product Description
Code | Description | Material | Specification | Packing |
JDF1001 | Petri Dish | PS | 90*15mm, one room, 3vents | 500PCS/CTN |
JDF1005 | Petri Dish | PS | 90*15mm, two rooms | 500PCS/CTN |
JDF1003 | Petri Dish | PS | 90*15mm, three rooms | 500PCS/CTN |
Application of the Petir Dish
You can browse our company's Web page to get more details and choose other plastic items.
Contact Us
- Tiantai Biolife Plastic Co., Ltd.
- Contact nameTina Jiang Chat Now
- Phone0086-576-83915353
- AddressPingqiao , Tiantai , zhejiang ,china, Taizhou, Zhejiang
Product Categories
| BLOOD COLLEACTION TUBE | CENTRIFUGATE TUBE | MEDICAL PRODUCTS | New Products |
| PETRI DISH | PILL BOX | PIPETTE TIPS | POP VIALS |
| SPECIMEN CONTAINER | TRANSFER PIPETTE |
New Products
-
plastic petri dish 90mm manufacturer
-
disposal sterile Plastic Petri dish 90mm
-
Petri dish with CE&ISO certificates
-
Disposable petri dishes,90x15mm petri dish
-
Disposable Petri dish 90*15mm ,Disposable Petri Dish
-
Sterile plastic Petri Dishes Disposable petri dish
-
Plastic Petri Dish for laboratory Use, Disposable Petri Dish
-
petri dish for laboratory
-
disposable medical use transport swab tube with amies transport medium,swab tube
-
disposable petri dish
-
6 case square Travel pill case
-
3 case Plastic Pill Box
Popular Searches
- plastic dish
- petri dish
- culture dish
- culture plate
- Plastic Petri Dish
- Disposable Plastic Petri Dish
- Plastic Sterile Petri Dish
- Elisa Plate
- plastic base plate
- polystyrene plate
- petri dish 90mm sterile
- Sterile Plastic Petri Dish
- Sterile Disposable Petri Dish
- Sterile Petri Dish Plastic
- plastic dishes
- glass petri dish
- disposable petri dish
- laboratory petri dish
- cell culture
- transparent plates
- sterile petri dish
- culture petri dish
- plastic petri dishes
- disposable petri dishes
- disposable plastic dishes
- disposable dishes
- petri
- circular dish
- petri dish glass
- petri culture dish
Recommended Products
- HC-K012A Laboratory Sterile Petri DIsh/ Medical Disposable plastic/glass petri dish
- Disposable plastic different size petri dish
- Factory direct laboratory supplies Disposable sterilized 90*15mm plastic petri dish
- Hot Sale Disposable Sterile Plastic 90*15mm Culture Petri Dish for Laboratory use
- ISO9001 Certificate PS polystyrene clear plastic contact dish E.O Sterile Three compartment 90mm plastic sterile petri dish
- ISO9001 Certificate PS polystyrene clear plastic contact dish E.O Sterile Three compartment 90mm plastic sterile petri dish
- Petri Dish and Other Laboratory Dishes
- chemical lab 130mm plastic or glass petri dish
- custom made 35mm quartz petri dish glass
- laboratory use round square glass petri dish
- cheap price glass sterile 75mm lab petri dish
- High quality glass/plastic petri dish glass dropper
Find Similar Products By Category
- Instruments & Meters > Lab Utensil and Disposable > Petri Dish
- Please Enter your Email Address
- Please enter the content for your inquiry.
We will find the most reliable suppliers for you according to your description.
Send Now
Tiantai Biolife Plastic Co., Ltd.
AIBot OnlineThis conversation is AI-generated. Contact manufacturer before transaction to confirm info.
-
Tina Jiang
Hi there! Welcome to my shop. Let me know if you have any questions.
Your message has exceeded the limit.
- Contact supplier for lowest price
- Customized Request
- Request Sample
- Request Free Catalogs
Your message has exceeded the limit.
-
Purchase Quantity
-
*Sourcing Details
Your inquiry content must be between 10 to 5000 characters.
-
*Email
Please enter Your valid email address.
-
Mobile





90*15mm three-room plastic petri dish
60*15mm plastic petri dish
Three-compact Lab Plastic Petri Dish 90*15mm
Disposable sterile plastic petri dish
90*15mm plastic petri dish
Petri dish 90mm /disposal sterile petri dish

plastic petri dish 90mm manufacturer
disposal sterile Plastic Petri dish 90mm
Petri dish with CE&ISO certificates
Disposable petri dishes,90x15mm petri dish
Disposable Petri dish 90*15mm ,Disposable Petri Dish
Sterile plastic Petri Dishes Disposable petri dish
Plastic Petri Dish for laboratory Use, Disposable Petri Dish
petri dish for laboratory
disposable medical use transport swab tube with amies transport medium,swab tube
disposable petri dish
6 case square Travel pill case
3 case Plastic Pill Box
Round 7 days pill box , plastic pill box
Weekly pill box
Pill Crusher and Splitter medical pill crusher
Tablet Taking tablet crusher blue clear
7 days pill box 7 compartment pill box
cute pill box 7days
Plastic pill box
Petri dish//petri dish 90mm
plastic round 7 day pill box//pill box
pill box
vitamin pill box /pill box